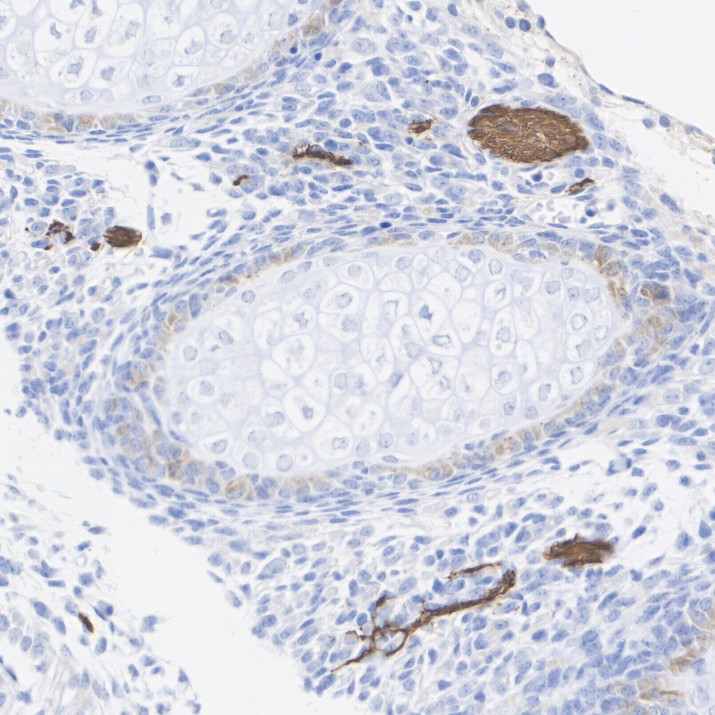

Safety datasheet
Overview
Product Name
Beta III Tubulin Recombinant Rabbit Monoclonal Antibody [PSH15-32]
Antibody Type
Recombinant Rabbit monoclonal Antibody
Immunogen
Synthetic peptide within mouse Beta III Tubulin aa 401-450.
Species Reactivity
Human, Mouse, Rat
Validated Applications
WB, IHC-P, IF-Tissue, IF-Cell, FC, IP
Molecular Weight
Predicted band size: 50 kDa
Positive Control
SH-SY5Y cell lysate, U-87 MG cell lysate, Neuro-2a cell lysate, Mouse brain tissue lysate, Rat brain tissue lysate, mouse neuron cells, human cerebellum tissue, mouse E14.5 embryo tissue, mouse cerebellum tissue, rat E14.5 embryo tissue, rat cerebellum tissue, SH-SY5Y, Neuro-2a.
Conjugation
unconjugated
Clone Number
PSH15-32
Reactivity Data
Tested Verified (internally validated)
Published Reported in literature (not internally validated)
Predicted Predicted reactive (based on sequence homology)
Not recommended Not recommended (failed internal validation)
| WB | IHC-P | IF-Tissue | IF-Cell | FC | IP | |
|---|---|---|---|---|---|---|
| Human |
|
|
|
|
|
|
| Mouse |
|
|
|
|
|
|
| Rat |
|
|
|
|
Product Features
Form
Liquid
Concentration
Storage Instructions
Shipped at 4℃. Store at +4℃ short term (1-2 weeks). It is recommended to aliquot into single-use upon delivery. Store at -20℃ long term.
Storage Buffer
1*PBS (pH7.4), 0.1% BSA, 40% Glycerol, 0.2% Proclean 950.
Isotype
IgG
Purification Method
Protein A affinity purified.
Application Dilution
-
WB
-
1:2,500
-
IHC-P
-
1:2,000-1:4,000
-
IF-Tissue
-
1:400
-
IF-Cell
-
1:500
-
FC
-
1:1,000-1:10,000
-
IP
-
1-2μg/sample
Target
Function
Tubulin beta-3 chain, Class III β-tubulin, βIII-tubulin (β3-tubulin) or β-tubulin III, is a microtubule element of the tubulin family found almost exclusively in neurons, and in testis cells. In humans, it is encoded by the TUBB3 gene. Forebrain neuronal culture after 40 days of differentiation from induced human pluripotent stem cells. Class III β-tubulin is one of the seven β-tubulin isotypes identified in the human genome, predominantly in neurons and the testis. It is conditionally expressed in a number of other tissues after exposure to a toxic microenvironment featured by hypoxia and poor nutrient supply. Posttranslational changes including phosphorylation and glycosylation are required for functional activity. Class III β-tubulin's role in neural development has warranted its use as an early biomarker of neural cell differentiation from multi potent progenitors. TUBB3 inactivation impairs neural progenitor proliferation. Rescue experiments demonstrate the non-interchangeability of TUBB3 with other classes of β-tubulins which cannot restore the phenotype resulting from TUBB3 inactivation. Congenital neurologic syndromes associated with TUBB3 missense mutations demonstrate the critical importance of class III β-tubulin for normal neural development.
Background References
1. Puri D et al. TUBB3 and KIF21A in neurodevelopment and disease. Front Neurosci. 2023 Aug
2. Jin S et al. TUBB3 M323V Syndrome Presents with Infantile Nystagmus. Genes (Basel). 2021 Apr
Subcellular Location
Cytoplasm, cytoskeleton, growth cone, lamellipodium, filopodium.
Synonyms
beta 3 tubulin antibody
beta 4 antibody
beta-4 antibody
CDCBM antibody
CDCBM1 antibody
CFEOM3 antibody
CFEOM3A antibody
FEOM3 antibody
M(beta)3 antibody
M(beta)6 antibody
Expandbeta 3 tubulin antibody
beta 4 antibody
beta-4 antibody
CDCBM antibody
CDCBM1 antibody
CFEOM3 antibody
CFEOM3A antibody
FEOM3 antibody
M(beta)3 antibody
M(beta)6 antibody
MC1R antibody
Neuron specific beta III Tubulin antibody
Neuron-specific class III beta-tubulin antibody
QccE-11995 antibody
QccE-15186 antibody
TBB3_HUMAN antibody
Tubb 3 antibody
TUBB3 antibody
TUBB4 antibody
Tubulin beta 3 antibody
Tubulin beta 3 chain antibody
Tubulin beta 4 antibody
Tubulin beta III antibody
Tubulin beta-3 chain antibody
Tubulin beta-4 chain antibody
Tubulin beta-III antibody
tuj 1 antibody
tuj1 antibody
CollapseImages
-

☑ Relative expression (RE)
Western blot analysis of Beta III Tubulin on different lysates with Rabbit anti-Beta III Tubulin antibody (HA723738) at 1/2,500 dilution.
Lane 1: SH-SY5Y cell lysate (15 µg/Lane)
Lane 2: HeLa cell lysate (negative) (15 µg/Lane)
Lane 3: U-87 MG cell lysate (15 µg/Lane)
Lane 4: Neuro-2a cell lysate (15 µg/Lane)
Lane 5: NIH/3T3 cell lysate (negative) (15 µg/Lane)
Lane 6: Mouse brain tissue lysate (20 µg/Lane)
Lane 7: Rat brain tissue lysate (20 µg/Lane)
Predicted band size: 50 kDa
Observed band size: 50 kDa
Exposure time: 4 seconds; ECL: K1801;
4-20% SDS-PAGE gel.
Proteins were transferred to a PVDF membrane and blocked with 5% NFDM/TBST for 1 hour at room temperature. The primary antibody (HA723738) at 1/2,500 dilution was used in primary antibody dilution (K1803) at 4℃ overnight. Goat Anti-Rabbit IgG - HRP Secondary Antibody (HA1001) at 1/50,000 dilution was used for 1 hour at room temperature. -

Application: IF-Tissue
Species: Mouse
Site: cerebellum
Sample: Paraffin-embedded section
Antibody concentration: 1/400 -

Application: IF-Tissue
Species: Rat
Site: cerebellum
Sample: Paraffin-embedded section
Antibody concentration: 1/400 -

Immunocytochemistry analysis of mouse neuron cells labeling Beta III Tubulin with Rabbit anti-Beta III Tubulin antibody (HA723738) at 1/500 dilution.
Cells were fixed in 4% paraformaldehyde for 15 minutes at room temperature, permeabilized with 0.1% Triton X-100 in PBS for 15 minutes at room temperature, then blocked with 1% BSA in 10% negative goat serum for 1 hour at room temperature. Cells were then incubated with Rabbit anti-Beta III Tubulin antibody (HA723738) at 1/500 dilution in 1% BSA in PBST overnight at 4 ℃. Goat Anti-Rabbit IgG H&L (iFluor™ 488, HA1121) was used as the secondary antibody at 1/1,000 dilution. PBS instead of the primary antibody was used as the secondary antibody only control. Nuclear DNA was labelled in blue with DAPI.
Beta tubulin (HA601187, red) was stained at 1/100 dilution overnight at +4℃. Goat Anti-Mouse IgG H&L (iFluor™ 594, HA1126) was used as the secondary antibody at 1/1,000 dilution. -

Immunohistochemical analysis of paraffin-embedded human cerebellum tissue with Rabbit anti-Beta III Tubulin antibody (HA723738) at 1/4,000 dilution.
The section was pre-treated using heat mediated antigen retrieval with Tris-EDTA buffer (pH 9.0) for 20 minutes. The tissues were blocked in 1% BSA for 20 minutes at room temperature, washed with ddH2O and PBS, and then probed with the primary antibody (HA723738) at 1/4,000 dilution for 1 hour at room temperature. The detection was performed using an HRP conjugated compact polymer system. DAB was used as the chromogen. Tissues were counterstained with hematoxylin and mounted with DPX. -

Immunohistochemical analysis of paraffin-embedded mouse E14.5 embryo tissue with Rabbit anti-Beta III Tubulin antibody (HA723738) at 1/4,000 dilution.
The section was pre-treated using heat mediated antigen retrieval with Tris-EDTA buffer (pH 9.0) for 20 minutes. The tissues were blocked in 1% BSA for 20 minutes at room temperature, washed with ddH2O and PBS, and then probed with the primary antibody (HA723738) at 1/4,000 dilution for 1 hour at room temperature. The detection was performed using an HRP conjugated compact polymer system. DAB was used as the chromogen. Tissues were counterstained with hematoxylin and mounted with DPX. -
Immunohistochemical analysis of paraffin-embedded mouse E14.5 embryo tissue with Rabbit anti-Beta III Tubulin antibody (HA723738) at 1/4,000 dilution.
The section was pre-treated using heat mediated antigen retrieval with Tris-EDTA buffer (pH 9.0) for 20 minutes. The tissues were blocked in 1% BSA for 20 minutes at room temperature, washed with ddH2O and PBS, and then probed with the primary antibody (HA723738) at 1/4,000 dilution for 1 hour at room temperature. The detection was performed using an HRP conjugated compact polymer system. DAB was used as the chromogen. Tissues were counterstained with hematoxylin and mounted with DPX. -

Immunohistochemical analysis of paraffin-embedded mouse cerebellum tissue with Rabbit anti-Beta III Tubulin antibody (HA723738) at 1/4,000 dilution.
The section was pre-treated using heat mediated antigen retrieval with Tris-EDTA buffer (pH 9.0) for 20 minutes. The tissues were blocked in 1% BSA for 20 minutes at room temperature, washed with ddH2O and PBS, and then probed with the primary antibody (HA723738) at 1/4,000 dilution for 1 hour at room temperature. The detection was performed using an HRP conjugated compact polymer system. DAB was used as the chromogen. Tissues were counterstained with hematoxylin and mounted with DPX. -

Immunohistochemical analysis of paraffin-embedded rat E14.5 embryo tissue with Rabbit anti-Beta III Tubulin antibody (HA723738) at 1/4,000 dilution.
The section was pre-treated using heat mediated antigen retrieval with Tris-EDTA buffer (pH 9.0) for 20 minutes. The tissues were blocked in 1% BSA for 20 minutes at room temperature, washed with ddH2O and PBS, and then probed with the primary antibody (HA723738) at 1/4,000 dilution for 1 hour at room temperature. The detection was performed using an HRP conjugated compact polymer system. DAB was used as the chromogen. Tissues were counterstained with hematoxylin and mounted with DPX. -

Immunohistochemical analysis of paraffin-embedded rat E14.5 embryo tissue with Rabbit anti-Beta III Tubulin antibody (HA723738) at 1/4,000 dilution.
The section was pre-treated using heat mediated antigen retrieval with Tris-EDTA buffer (pH 9.0) for 20 minutes. The tissues were blocked in 1% BSA for 20 minutes at room temperature, washed with ddH2O and PBS, and then probed with the primary antibody (HA723738) at 1/4,000 dilution for 1 hour at room temperature. The detection was performed using an HRP conjugated compact polymer system. DAB was used as the chromogen. Tissues were counterstained with hematoxylin and mounted with DPX. -

Immunohistochemical analysis of paraffin-embedded rat cerebellum tissue with Rabbit anti-Beta III Tubulin antibody (HA723738) at 1/4,000 dilution.
The section was pre-treated using heat mediated antigen retrieval with Tris-EDTA buffer (pH 9.0) for 20 minutes. The tissues were blocked in 1% BSA for 20 minutes at room temperature, washed with ddH2O and PBS, and then probed with the primary antibody (HA723738) at 1/4,000 dilution for 1 hour at room temperature. The detection was performed using an HRP conjugated compact polymer system. DAB was used as the chromogen. Tissues were counterstained with hematoxylin and mounted with DPX. -

☑ Relative expression (RE)
Immunocytochemistry analysis of SH-SY5Y (positive) and HeLa (negative) labeling Beta III Tubulin with Rabbit anti-Beta III Tubulin antibody (HA723738) at 1/500 dilution.
Cells were fixed in 4% paraformaldehyde for 15 minutes at room temperature, permeabilized with 0.1% Triton X-100 in PBS for 15 minutes at room temperature, then blocked with 1% BSA in 10% negative goat serum for 1 hour at room temperature. Cells were then incubated with Rabbit anti-Beta III Tubulin antibody (HA723738) at 1/500 dilution in 1% BSA in PBST overnight at 4 ℃. Goat Anti-Rabbit IgG H&L (iFluor™ 488, HA1121) was used as the secondary antibody at 1/1,000 dilution. PBS instead of the primary antibody was used as the secondary antibody only control. Nuclear DNA was labelled in blue with DAPI.
Beta tubulin (HA601187, red) was stained at 1/100 dilution overnight at +4℃. Goat Anti-Mouse IgG H&L (iFluor™ 594, HA1126) was used as the secondary antibody at 1/1,000 dilution. -

Immunocytochemistry analysis of Neuro-2a cells labeling Beta III Tubulin with Rabbit anti-Beta III Tubulin antibody (HA723738) at 1/500 dilution.
Cells were fixed in 4% paraformaldehyde for 15 minutes at room temperature, permeabilized with 0.1% Triton X-100 in PBS for 15 minutes at room temperature, then blocked with 1% BSA in 10% negative goat serum for 1 hour at room temperature. Cells were then incubated with Rabbit anti-Beta III Tubulin antibody (HA723738) at 1/500 dilution in 1% BSA in PBST overnight at 4 ℃. Goat Anti-Rabbit IgG H&L (iFluor™ 488, HA1121) was used as the secondary antibody at 1/1,000 dilution. PBS instead of the primary antibody was used as the secondary antibody only control. Nuclear DNA was labelled in blue with DAPI.
Beta tubulin (HA601187, red) was stained at 1/100 dilution overnight at +4℃. Goat Anti-Mouse IgG H&L (iFluor™ 594, HA1126) was used as the secondary antibody at 1/1,000 dilution. -

☑ Relative expression (RE)
Flow cytometric analysis of HeLa (left, negative) and SH-SY5Y (right, positive) cells labeling Beta III Tubulin.
Cells were fixed and permeabilized. Then stained with the primary antibody (HA723738, 1/10,000) (red) compared with Rabbit IgG Isotype Control (green). After incubation of the primary antibody at +4℃ for an hour, the cells were stained with a iFluor™ 488 conjugate-Goat anti-Rabbit IgG Secondary antibody (HA1121) at 1/1,000 dilution for 30 minutes at +4℃. Unlabelled sample was used as a control (cells without incubation with primary antibody; black). -

Flow cytometric analysis of Neuro-2a cells labeling Beta III Tubulin.
Cells were fixed and permeabilized. Then stained with the primary antibody (HA723738, 1/1,000) (red) compared with Rabbit IgG Isotype Control (green). After incubation of the primary antibody at +4℃ for an hour, the cells were stained with a iFluor™ 488 conjugate-Goat anti-Rabbit IgG Secondary antibody (HA1121) at 1/1,000 dilution for 30 minutes at +4℃. Unlabelled sample was used as a control (cells without incubation with primary antibody; black). -

Beta III Tubulin was immunoprecipitated from 0.2 mg mouse brain tissue lysate with HA723738 at 2 µg/10 µl beads. Western blot was performed from the immunoprecipitate using HA723738 at 1/500 dilution. HRP Conjugated Anti-Rabbit IgG for IP Nano-secondary antibody at 1/5,000 dilution was used for 1 hour at room temperature.
Lane 1: mouse brain tissue lysate (input)
Lane 2: HA723738 IP in mouse brain tissue lysate
Lane 3: Rabbit IgG instead of HA723738 in mouse brain tissue lysate
Blocking/Dilution buffer: primary antibody dilution (K1803)
Exposure time: 7 seconds; ECL: K1801
Please note: All products are "FOR RESEARCH USE ONLY AND ARE NOT INTENDED FOR DIAGNOSTIC OR THERAPEUTIC USE"
Citation
-
Molecular Gardening for Neuroinflammation via Nose-to-Brain Delivery: A Ca2+ Responsive DNA Nanocage-Hydrogel System With Neuron Targeting and STING Inhibiting
Journal: Advanced Materials
DOI: 10.1002/adma.202518814
IF: 26.8
Application: IF-cell
Reactivity: Rat
Publish date: 2026 Jan
Products with the same target and pathway
Beta III Tubulin Rabbit Polyclonal Antibody
Application: WB,IF-Cell,IHC-P,FC,IF-Tissue
Reactivity: Human,Mouse,Rat
Conjugate: unconjugated
Beta III Tubulin Recombinant Rabbit Monoclonal Antibody [SP06-00]
Application: WB,IHC-P,IP,FC,IHC-Fr,IF-Cell
Reactivity: Human,Mouse,Rat
Conjugate: unconjugated
iFluor™ 594 Conjugated Beta III Tubulin Mouse Monoclonal Antibody [A8-D10]
Application: IF-Tissue,IF-Cell,FC
Reactivity: Human,Rat
Conjugate: iFluor™ 594
Beta III Tubulin Rabbit Polyclonal Antibody
Application: WB,IF-Cell,FC
Reactivity: Human,Mouse,Rat
Conjugate: unconjugated
Beta III Tubulin Recombinant Rabbit Monoclonal Antibody [PSH15-32] - BSA and Azide free
Application: WB,IHC-P,IF-Tissue,IF-Cell,FC,IP
Reactivity: Human,Mouse,Rat
Conjugate: unconjugated
Beta III Tubulin Recombinant Rabbit Monoclonal Antibody [SP06-00] - BSA and Azide free
Application: WB,IHC-P,IP,FC,IHC-Fr,IF-Cell
Reactivity: Human,Mouse,Rat
Conjugate: unconjugated
iFluor™ 488 Conjugated Beta III Tubulin Mouse Monoclonal Antibody [A8-D10]
Application: IF-Cell,FC,IF-Tissue
Reactivity: Human,Mouse,Rat
Conjugate: iFluor™ 488
Beta III Tubulin Rabbit Polyclonal Antibody
Application: WB,IF-Cell,IHC-P,FC
Reactivity: Human,Mouse,Rat
Conjugate: unconjugated
Beta III Tubulin Mouse Monoclonal Antibody [A8-D10]
Application: WB,IF-Cell,IHC-P,FC,IF-Tissue
Reactivity: Human,Mouse,Rat
Conjugate: unconjugated












